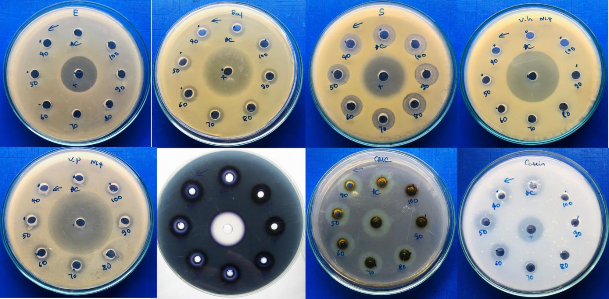
Hình 4 7 Khả năng kháng các chủng vi khuẩn kiểm định của chủng N1 4 trên 1
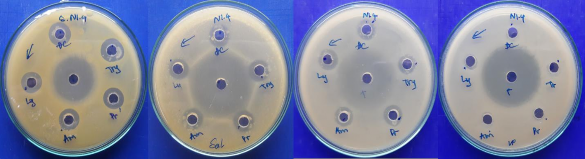
Hình 4 7 Khả năng kháng các chủng vi khuẩn kiểm định của chủng N1 4 trên 2

ở nhiệt độ 45oC. Bổ sung thêm tinh bột tan để được chế phẩm bột có mật độ (2x109 cfu/g).
Phần dịch nổi được lọc qua minipore (0.45µm), thu dịch lọc chứa bacteriocin.
Bước 5: Dịch lọc được thu và tủa với muối sunfat amon 70% xử lý ở 4oC qua đêm, thẩm tích, thu dịch protein.
Bước 5: Dịch protein sau thẩm tích được chiết với ethyl acetate tỷ lệ 1/1, lắc 30 phút, ở điều kiện phòng 25oC.
Bước 6: Phân đoạn dung môi được thu và loại bỏ dung môi bằng hệ thống máy cô quay (30 rpm) và hút chân không ở 55oC, phần cặn còn lại được hoàn nguyên trong đệm phosphate để nghiên cứu tiếp.
Bước 7: Cặn pha lại trong đệm phốt phát pH7, thử hoạt tính và nghiên cứu.
Sản phẩm bacteriocins có độ sạch gấp 46 lần so với ban đầu.
4.4.2. Ảnh hưởng của nhiệt độ đến độ bền của bacteriocin
Dịch nổi sau lên men chủng N1.4 được ủ ở các nhiệt độ khác nhau trong dải từ 40-100°C. Sau đó thực hiện kiểm tra hoạt tính kháng khuẩn và hoạt tính enzyme.
Bảng 4.9. Ảnh hưởng của nhiệt độ đến hoạt tính kháng khuẩn
Hoạt tính ức chế còn lại (%) | |||||
Nhiệt độ (oC) | E.coli | Salmonella | S.aureus | V.harveyi | V.paraheamolyticus |
Không xử lý nhiệt (đ/c ở 37oC) | 0 | 100 | 100 | 0 | 100 |
40 | 0 | 100 | 100 | 75 | |
50 | 0 | 100 | 100 | 75 | |
60 | 0 | 100 | 100 | 75 | |
70 | 0 | 100 | 100 | 75 | |
80 | 0 | 75 | 100 | 50 | |
90 | 0 | 75 | 100 | 50 | |
100 | 0 | 50 | 100 | 0 |
Có thể bạn quan tâm!
-
Định Danh Chủng Vi Sinh Vật Có Khả Năng Sinh Tổng Hợp Bacteriocin Đã Được Tuyển Chọn -
Khả Năng Sinh Tổng Hợp Enzyme Amylase, Cellulase Và Protease -
Cây Phát Sinh Chủng Loại Của Chủng Vi Khuẩn Chọn Lọc N1.4 Với Các Trình Tự Gen Trên Genbank Có Mức Độ Tương Đồng Cao Nhất -
Phân lập và tuyển chọn chủng probiotic sinh tổng hợp bacteriocin từ ruột tôm nước mặn tỉnh Nam Định để ứng dụng trong sản xuất thức ăn chăn nuôi tôm - 9
Xem toàn bộ 81 trang tài liệu này.
Từ kết quả thí nghiệm cho thấy, sau khi xử lý với nhiệt ở các nhiệt độ khác nhau, hoạt tính kháng các chủng vi khuẩn kiểm định Salmonella và V.paraheamolyticus giảm dần trong dải nhiệt độ ủ và thấp hơn đối chứng, hoạt tính kháng bắt đầu giảm từ > 80°C.
Dịch lên men của chủng N1.4 có khả năng kháng mạnh các chủng của Salmonella, S.aureus V.paraheamolyticus, nhưng không có khả năng kháng hai chủng của V.harveyi và E.coli.
Khả năng kháng các chủng vi khuẩn kiểm định của chủng N1.4 trên môi trường LB và khả năng sinh tổng hợp enzyme trên các môi trường chứa cơ chất đặc hiệu ở 37°C sau 24 giờ được thể hiện trên hình 4.7.
Với kết quả thử hoạt tính enzyme trên 3 loại cơ chất khác nhau cho thấy, 2 enzyme amylase và protease đều mất hoạt tính ở >70°C, với cellulase là 100°C. Hoạt tính enzyme amylase trước và sau khi ủ đều yếu. Ở dải nhiệt độ 37-70°C, hoạt tính enzyme cellulase không có sự thay đổi so với đối chứng (không xử lý nhiệt) và giảm dần từ 80°C.
Hình 4.7. Khả năng kháng các chủng vi khuẩn kiểm định của chủng N1.4 trên môi trường LB và khả năng sinh tổng hợp enzyme trên các môi trường chứa cơ chất đặc hiệu
4.4.3. Ảnh hưởng của pH đến độ bền của dịch bacteriocin và hoạt tính enzyme
Dịch lên men chủng N1.4 được điều chỉnh bằng HCl hoặc NaOH 1N ở các pH khác nhau trong dải từ 3-12 ở 37°C. Sau 2 giờ, dịch lên men được trung hoà về pH ban đầu và đưa đi ly tâm ở 10000 rpm/min trong 5 phút rồi kiểm tra hoạt tính kháng khuẩn và hoạt tính enzyme (bảng 4.10).
Bảng 4.10. Ảnh hưởng của pH đến hoạt tính kháng khuẩn
Hoạt tính kháng khuẩn còn lại (%) sau xử lý ở pH khác nhau | |||||
pH | E.coli | Salmonella | S.aureus | V.harveyi | V.paraheamolyticus |
3 | 0 | 75 | 100 | 0 | 0 |
4 | 0 | 75 | 100 | 0 | 0 |
5 | 0 | 75 | 100 | 0 | 40 |
6 | 0 | 75 | 100 | 0 | 75 |
7 (đ/c) | 0 | 100 | 100 | 0 | 75 |
8 | 0 | 100 | 100 | 0 | 75 |
9 | 0 | 100 | 100 | 0 | 75 |
10 | 0 | 75 | 100 | 0 | 75 |
11 | 0 | + | 100 | 0 | 0 |
12 | 0 | - | 83,88 | 0 | 0 |
Từ kết quả nghiên cứu cũng cho thấy, hoạt tính kháng các chủng vi khuẩn kiểm định có sự khác nhau giữa các chủng.
Sau khi được xử lí trong dải pH từ 3-12, dịch lên men của chủng phân lập vẫn có khả năng kháng S.aureus, Salmonella, V.paraheamolyticus và hoạt tính giảm nhẹ ở pH trong các khoảng 3-5 và 11-12.
Ảnh hưởng của enzyme thủy phân (protease) đến hoạt tính của bacteriocin
Dịch lên men chủng N1.4 được ly tâm ở 10000 rpm/min trong 5 phút và thu dịch nổi. Sau đó, dịch nổi được xử lý bởi các enzyme khác nhau là Lysozyme, Amylase, Protease và Trypsin ở nồng độ cuối là 1g/L và ủ ở 37°C trong 2 h. Dịch
sau xử lý được dùng để đánh giá hoạt tính kháng khuẩn, kết quả được trình bày trên bảng 4.11.
Bảng 4.11. Ảnh hưởng của protease đến hoạt tính kháng khuẩn của bacteriocin
Hoạt tính (%) kháng khuẩn còn lại sau xử lý bởi protease | ||||
Enzyme | Salmonella typhi | S.aureus | V.harveyi | V.paraheamolytic us |
ĐC | 100 | 100 | - | 100 |
Lysozyme | 83,33 | 83,33 | - | 100 |
Amylase | 100 | 75 | - | 75 |
Protease K | 100 | 75 | - | 100 |
Trypsin | 100 | 100 | - | 100 |
Hình 4.7. Khả năng kháng các chủng vi khuẩn kiểm định của chủng N1.4 trên môi trường ở 37°C
Từ kết quả thu được cho thấy, các enzyme hầu như không có ảnh hưởng lớn tới hoạt tính kháng các chủng vi khuẩn kiểm định. Kết quả sau xử lí có sự thay đổi không đáng kể so với mẫu đối chứng.
KẾT LUẬN VÀ ĐỀ NGHỊ
Kết luận:
- Quá trình phân lập đã thu được một số chủng có khả năng kháng khuẩn cao từ ruột tôm nước mặn, trong đó chủng N1.4 là chủng cho hoạt tính kháng khuẩn cao và ổn định nhất trong số 50 chủng phân lập.
- Kết quả phân tích một phần trình tự nucleotide vùng V1-V9 của 16S RNA ribosomal của chủng chọn lọc N1.4 có độ tương đồng cao (99%) so với loài Bacillus subtilis.
- Khi kết hợp các yếu tố môi trường LB g/l ( pepton 10, cao thịt bò 10, NaCl
5) và có bổ sung CaCl2, ZnSO4 mỗi loại 1 mM, pH 7,0, nuôi lắc 180 vòng/phút, ở 37oC, 48 giờ lên men, tỷ lệ tiếp giống 107 cfu/ml cho hoạt tính cao 381 AU/ml.
- Chủng N1.4 có khả năng sinh tổng hợp bacteriocin cao nhất sau 48 giờ lên men, kháng S.aureus ATCC 25923, Salmonella typhi, V.paraheamolyticus. Bacteriocin ổn định trong khoảng nhiệt độ 37-70°C, pH 6-10 và không nhạy cảm với protease (hoạt tính bacteriocin bền khi xử lý với Lysozyme, Amylase, Protease K, Trypsin), sau xử lý vẫn duy trì khả năng kháng vi khuẩn Salmonella typhi, S.aureus, V.paraheamolyticus.
Đề nghị:
Tiếp tục thực hiện các nghiên cứu thu nhận chế phẩm bacteriocin quy mô pilot và sản xuất qui mô công nghiệp. Chế phẩm sinh học Bacteriocin sẽ được sản xuất và đóng gói, thương mại, ứng dụng rộng rãi trên thị trường, có thể chủ động bổ sung trực tiếp vào thức ăn chăn nuôi tôm với một lượng đủ để tăng cường tiêu hoá, giảm hại khuẩn, cân bằng hệ vi sinh đường ruột, tăng cường sức khoẻ và kháng bệnh cho tôm một cách phù hợp và hiệu quả, đáp ứng xu thế phát triển ngành nuôi trồng thuỷ sản và phát triển kinh tế - xã hội Việt nam và đảm bảo chất lượng để xuất khẩu tôm đi tất cả các quốc gia trên thế giới .
TÀI LIỆU THAM KHẢO
1. Bộ Nông nghiệp và phát triển nông thôn (2021). Hiệu quả mô hình nuôi tôm siêu thâm canh công nghệ cao.
2. Lại Thúy Hiền (1998). “Một số đặc điểm sinh lí, sinh hóa của một số chủng vi khuẩn khử sulphat phân lập từ mỏ dầu Bạch Hổ”, Tạp chí sinh học, 8: 33-38
3. Lê Thị Trúc Linh (2016). “Xác định các gen đích trực tiếp của microRNA -144 trong tế bào chondrocyte”, Tạp chí Khoa học và Công nghệ, 29(4), 133 – 139.
4. Lê Văn Cát, Đỗ Thị Hồng Nhung, Ngô Ngọc Cát (2006), Nước nuôi thủy sản: Chất lượng và biện pháp cải thiện chất lượng, Nhà xuất bản Khoa học và Kỹ thuật, Hà Nội.
5. Ngô Tự Thành (2001), “Sự phân bố, sinh trưởng và sinh tổng hợp protease ngoại bào của Bacillus ở vùng Hà Nội”, Tạp chí sinh học 23: 153-157.
6. Nguyễn Hữu Thọ (2001), “Biến động của sulfite, ammonia, nitrite, BOD, COD, chlo hữu cơ trong môi trường nước ảnh hưởng đến khả năng xảy ra bệnh đốm trắng, bệnh đàu vàng trên tôm nuôi ở Khánh Hòa”. Tạp chí thủy sản, 43, Bộ Thủy sản - Trung tâm nghiên cứu thủy sản III: 5-15.
7. Nguyễn Lân Dũng, Nguyễn Đình Quyến, Phạm Văn Ty (2002), Vi sinh vật học,
NXB Giáo dục, Hà Nội.
8. Vũ Trung Tạng (2001), Cơ sở sinh thái học, Nhà xuất bản giáo dục, Hà Nội.
9. Austin, B.; Zhang, X.H., (2006), "Vibrio harveyi: a significant pathogen of marine vertebrates and invertebrates”, Lett. Appl. Microbiol., 43, 119–124.
10.Balcázar, J.L.; Blas, I.d.; Ruiz-Zarzuela, I.; Cunningham, D.; Vendrell, D.; Múzquiz, J.L., (2006), “The role of probiotics in aquaculture”. Vet. Microbiol., 114, 173–186.
11.Bomba, A.; Nemcová, R.; Mudronová, D.; Guba, P., (2002), “The possibilities of potentiating the efficacy of probiotics”, Trends Food Sci. Technol., 13, 121–126. 12.Boyd C. E. and Tucker C. S. (1998). “Pond aquaculture water quality
Management”, Kluwer Academic Publishers, London, pp. 5.
13.Cabello, F.C., (2006), “Heavy use of prophylactic antibiotics in aquaculture: a growing problem for human and animal health and for the environment”, Environ. Microbiol., 8, 1137–1144.
14.Cahill, M.M. (1990), “Bacterial flora of fishes: A review”, Microb. Ecol., 19, 21– 41.
15.Daba et al., (1991). “Detection and Activity of a Bacteriocin Produced by
Leuconostoc mesenteroides”, Applied microbiology and biotechnology 15 (3): 228
- 233.
16.De Vuyst, L. (1994), “Nisin production variability between natural Lactococcus lactis subsp. lactics strains”, Biotechnol. Lett, 16: pp. 287 – 292
17.Dorrington, T.; Gomez-Chiarri, M. (2008), “Antimicrobial Peptides for Use in Oyster Aquaculture: Effect on Pathogens, Commensals, and Eukaryotic Expression Systems”, J. Shellfish Res., 27, 365–374.
18.Ercolini, D., G. Moschetti, G. Blaiotta, S. Coppola. (2001), “Behavior of variable V3 region from 16S rDNA of lactic acid bacteria in denaturing gradient gel electrophoresis”, Curr. Microbiol. 42, 199-202.
19.Flegel, T.W., (2012), “Historic emergence, impact and current status of shrimp pathogens in Asia”, Journal of Invertebrate Pathology 110:166-173.
20.Fooks, L.J., R. Fuller, G.R. Gibson. (1999), Prebiotics, probiotics and human gut microbiol. 22, 133-144
21.Fuller, R., (1989), “Probiotics in man and animals”, J. Appl. Microbiol., 66, 365– 378.
22.Holzapfel, W.H., P.Haberer, R. Geisen, J. Bjorkroth, U. Schillinger. (2001). “Taxonomy and important features of probiotic microorganisms in food nutrition”, Am. J. Clin. Nutr. 73, 365S-373S.
23.Joerger, R.D. , (2003), “Alternatives to antibiotics: bacteriocin, antimicrobial peptides and bacteriophages”, Poult. Sci., 82, 640–647.
24.Karpiński T.M., A.K. Szkaradkiewicz, (2016), Bacteriocin in Encyclopedia of Food and Health.
25.Karthikeyan, V., S.W. Santosh. (2009). “Isolation and partila characterization of bacteriocin produced from Lactobacillus plantarum”, African Journal of Microbiology Research, Vol 3: pp. 233 – 239.
26.Kesarcodi-W, A.; Kaspar, H.; Lategan, M.J.; Gibson, L. , (2008), “Probiotics in aquaculture: The need, principles and mechanisms of action and screening processes”, Aquaculture, 274, 1–14.
27.Kurath, G. (2008), “Biotechnology and DNA vaccines for aquatic animals”, Rev. Sci. Tech. Off. Int. Epiz., 27, 175–196.
28.Lightner, D.V., R. M. Redman, C. R. Pantoja, ph.D., B. L. Noble, Loc Tran, (2012), “Early Mortality Syndrome Affects Shrimp in Asia”, Global Aquaculture Advocate, January/February 2012:40.
29.Loc Tran, L. Nunan, R. M. Redman, L. L. Mohney, C. R. Pantoja, K. Fitzsimmons,
D. V. Lightner, (2013), “Determination of the infectious nature of the agent of acute hepatopancreatic necrosis syndrome affecting penaeid shrimp”, Diseases of aquatic organisms. 105: 45–55.
30.Marcogliese, D. , (2008), “The impact of climate change on the parasites and infectious diseases of aquatic animals”, Rev. Sci. Tech. Off. Int. Epiz., 27, 467– 484.
31.Moriarty, D.J.W. , (1998), “Control of luminous Vibrio species in penaeid aquaculture ponds”, Aquaculture, 164, 351–358.
32.Musa, H.H.; Wu, S.L.; Zhu, C.H.; Seri, H.I.; Zhu, G.Q. (2009), “The Potential Benefits of Probiotics in Animal Production and Health”, J. Anim. Vet. Adv., 8, 313–321.
33.Parker, R.B., (1974), “Probiotics, the other half of the antibiotic story”, Anim. Nutr. Health, 29, 4–8.




